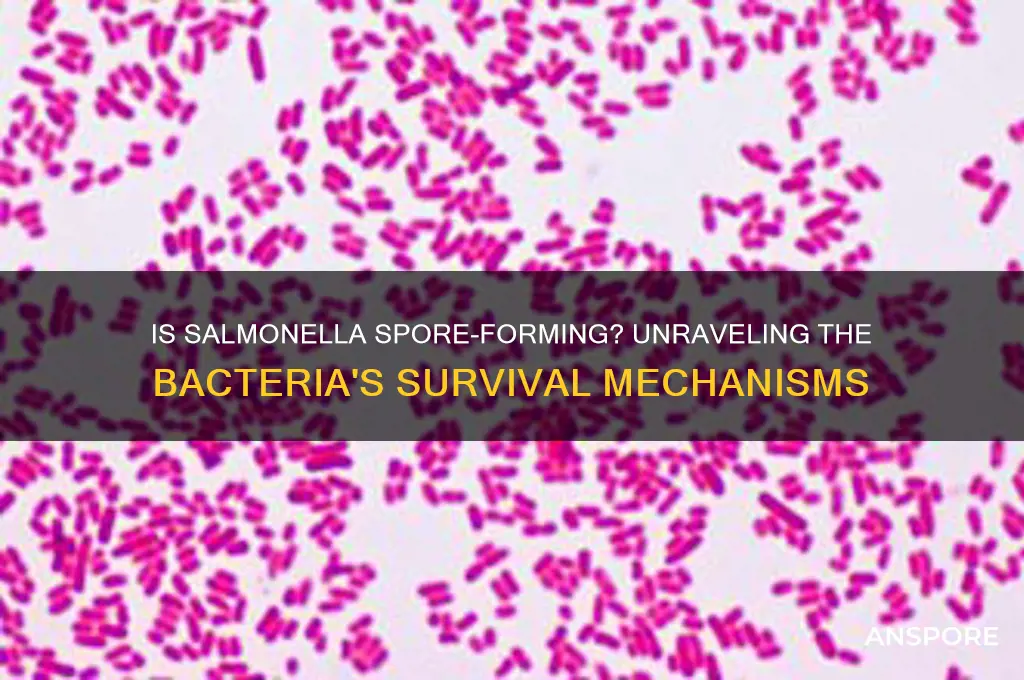
is salmonella a spore forming bacteria

Salmonella is a well-known bacterial pathogen primarily associated with foodborne illnesses, often causing symptoms like diarrhea, fever, and abdominal cramps. While it is a significant public health concern, Salmonella is not classified as a spore-forming bacterium. Spore formation is a survival mechanism employed by certain bacteria, such as Clostridium and Bacillus species, to endure harsh environmental conditions. Unlike these bacteria, Salmonella lacks the ability to produce spores, relying instead on its resilience and ability to survive in various environments, including food products, to persist and cause infections. Understanding this distinction is crucial for implementing effective food safety measures and controlling Salmonella outbreaks.
| Characteristics | Values |
|---|---|
| Spore Formation | No, Salmonella is not a spore-forming bacterium. |
| Classification | Gram-negative, facultative anaerobe, rod-shaped (bacillus). |
| Optimal Growth Temperature | 35-37°C (mesophile). |
| Survival Outside Host | Can survive for weeks in dry environments but does not form spores. |
| Resistance Mechanisms | Acid tolerance, biofilm formation, and antibiotic resistance (not spores). |
| Common Habitats | Intestinal tracts of animals, contaminated food, water, and surfaces. |
| Disease Caused | Salmonellosis (gastrointestinal illness). |
| Disinfection Susceptibility | Susceptible to heat, desiccation, and common disinfectants (unlike spores). |
| Genetic Traits | Does not possess genes for sporulation. |
| Clinical Significance | Leading cause of foodborne illness worldwide. |
What You'll Learn
- Salmonella's Classification: Salmonella is a non-spore forming, Gram-negative bacterium belonging to the Enterobacteriaceae family
- Spore Formation Process: Sporulation is a survival mechanism seen in bacteria like Clostridium, not Salmonella
- Salmonella Survival: Salmonella survives in harsh conditions via biofilms, not spore formation, unlike Bacillus species
- Heat Resistance: Salmonella is heat-sensitive; spore-formers like Clostridium botulinum are more heat-resistant
- Food Safety Implications: Non-spore forming nature of Salmonella limits its survival in processed foods compared to spore-formers

Salmonella's Classification: Salmonella is a non-spore forming, Gram-negative bacterium belonging to the Enterobacteriaceae family
Salmonella's classification as a non-spore forming bacterium is a critical distinction in microbiology, particularly when considering its survival and transmission mechanisms. Unlike spore-forming bacteria such as *Clostridium botulinum*, which can withstand extreme conditions by forming dormant spores, Salmonella relies on its ability to thrive in specific environments, primarily the intestinal tracts of animals and humans. This characteristic influences its role in foodborne illnesses, as it requires viable cells to cause infection, typically through contaminated food or water. Understanding this classification helps in designing effective control measures, such as proper cooking temperatures (e.g., 165°F or 74°C for poultry) to eliminate the bacterium.
From a taxonomic perspective, Salmonella's placement in the *Enterobacteriaceae* family underscores its close relationship to other intestinal pathogens like *Escherichia coli*. This Gram-negative classification is significant because it dictates the bacterium's susceptibility to certain antibiotics and disinfectants. For instance, Salmonella is generally susceptible to antimicrobials targeting its outer membrane, such as quinolones or third-generation cephalosporins. However, the rise of multidrug-resistant strains, particularly in livestock, complicates treatment and highlights the need for prudent antibiotic use in agriculture and healthcare settings.
The absence of spore formation in Salmonella also has implications for its environmental persistence. While it can survive for weeks in dry environments like contaminated surfaces or soil, it is less resilient than spore-forming bacteria, which can endure for years. This makes sanitation practices, such as regular cleaning with chlorine-based disinfectants (e.g., 100–200 ppm chlorine solution), highly effective in reducing Salmonella contamination in food processing facilities. Additionally, proper hand hygiene, especially after handling raw meat or poultry, is crucial to prevent cross-contamination.
Comparatively, the non-spore forming nature of Salmonella contrasts with bacteria like *Bacillus cereus*, which can cause foodborne illness through spore germination. This difference influences the strategies used to control these pathogens. For Salmonella, prevention focuses on interrupting transmission routes, such as ensuring safe water supplies and practicing good hygiene during food preparation. In contrast, controlling spore-forming bacteria often involves heat treatments (e.g., boiling or pasteurization) to destroy spores before they can germinate.
In practical terms, knowing Salmonella's classification empowers individuals and industries to implement targeted interventions. For example, food handlers should be trained to avoid time-temperature abuse (keeping food in the "danger zone" of 40°F–140°F or 4°C–60°C for extended periods), as this allows Salmonella to multiply rapidly. Similarly, travelers to regions with poor sanitation should be cautious about consuming raw or undercooked foods, as Salmonella is a common cause of traveler’s diarrhea. By focusing on these specific risks, the impact of Salmonella infections can be significantly reduced.
Do Dried Magic Mushrooms Contain Active, Living Spores?
You may want to see also

Spore Formation Process: Sporulation is a survival mechanism seen in bacteria like Clostridium, not Salmonella
Sporulation, the process of forming spores, is a remarkable survival strategy employed by certain bacteria to endure harsh environmental conditions. Unlike Salmonella, which relies on other mechanisms to survive outside a host, bacteria like Clostridium and Bacillus undergo a complex transformation to produce highly resistant spores. This process involves a series of morphological and biochemical changes, culminating in the creation of a dormant, protective structure capable of withstanding extreme temperatures, desiccation, and chemical disinfectants. Understanding sporulation is crucial for distinguishing between bacterial species and their survival capabilities.
The sporulation process begins with an asymmetric cell division, where the bacterial cell divides into a larger mother cell and a smaller forespore. This division is tightly regulated by a network of genes, ensuring the precise allocation of cellular components. As the forespore matures, it becomes engulfed by the mother cell, which then synthesizes a thick, multi-layered spore coat and an outer exosporium. These layers provide the spore with its characteristic resilience. For instance, the spore coat of *Bacillus subtilis* contains over 70 proteins, each contributing to its durability. This intricate process highlights the sophistication of bacterial survival strategies, contrasting sharply with non-spore-forming bacteria like Salmonella, which lack such elaborate protective mechanisms.
From a practical standpoint, the ability to form spores has significant implications for food safety and healthcare. Spores can survive in food processing environments, such as canned goods, where high temperatures and preservatives are used to eliminate vegetative bacteria. For example, *Clostridium botulinum* spores can survive boiling temperatures and germinate under anaerobic conditions, leading to botulism if ingested. In contrast, Salmonella, being non-spore-forming, is more susceptible to heat and disinfection, though it can still survive for weeks in dry environments. This distinction underscores the importance of tailored control measures: while thorough cooking (e.g., heating to 75°C for at least 15 seconds) effectively kills Salmonella, eradicating spores requires more extreme conditions, such as 121°C for 3 minutes in an autoclave.
Comparatively, the absence of sporulation in Salmonella limits its long-term survival in adverse conditions but does not diminish its public health impact. Salmonella relies on biofilm formation, stress response systems, and host adaptation to persist in environments. For instance, Salmonella can survive in low-moisture foods like spices and pet treats, posing risks to consumers. However, its vulnerability to heat and disinfectants makes it more manageable in food processing compared to spore-forming pathogens. This comparison highlights the need for targeted interventions: while Salmonella outbreaks can be controlled through proper hygiene and cooking practices, spore-forming bacteria require more stringent measures, such as spore-specific sanitizers and rigorous sterilization protocols.
In conclusion, sporulation is a specialized survival mechanism that sets certain bacteria apart from non-spore-forming species like Salmonella. While Salmonella poses significant health risks through its ability to adapt and persist, it lacks the extreme resilience conferred by spore formation. Recognizing this difference is essential for developing effective strategies to combat bacterial contamination. Whether in food safety, healthcare, or environmental management, understanding the unique survival tactics of bacteria enables more precise and efficient control measures, ultimately safeguarding public health.
Glutaraldehyde's Effectiveness: Can It Eliminate Spores Effectively?
You may want to see also

Salmonella Survival: Salmonella survives in harsh conditions via biofilms, not spore formation, unlike Bacillus species
Salmonella, a notorious foodborne pathogen, has evolved remarkable strategies to endure harsh environments, but it does not form spores—a survival mechanism famously employed by Bacillus species. Instead, Salmonella relies on biofilms, complex communities of bacteria encased in a protective extracellular matrix. This distinction is critical for understanding how Salmonella persists in food processing facilities, water systems, and even on kitchen surfaces, posing ongoing risks to public health.
Biofilms enable Salmonella to withstand extreme conditions such as desiccation, disinfectants, and temperature fluctuations. For instance, studies show that Salmonella biofilms can survive on stainless steel surfaces for up to 48 hours, even after exposure to sanitizers like quaternary ammonium compounds. In contrast, Bacillus species form spores, which are highly resistant dormant structures capable of surviving for years in adverse conditions. While spores are a more robust survival mechanism, Salmonella’s biofilm strategy is equally effective in its ecological niche, particularly in moist environments like food processing equipment or contaminated produce.
To combat Salmonella’s biofilm-mediated survival, targeted interventions are essential. Mechanical removal of biofilms through scrubbing or high-pressure washing is more effective than chemical sanitizers alone. Additionally, incorporating biofilm-disrupting agents like enzymes or surfactants into cleaning protocols can enhance eradication efforts. For example, the enzyme DNase has been shown to degrade the extracellular DNA component of Salmonella biofilms, reducing their structural integrity.
Understanding the difference between Salmonella’s biofilm formation and Bacillus’s spore formation has practical implications for food safety. While spores require extreme measures like autoclaving (121°C for 15 minutes) for inactivation, Salmonella biofilms can often be controlled through rigorous hygiene practices and regular monitoring of high-risk surfaces. However, complacency is dangerous; even small biofilm colonies can serve as reservoirs for contamination, emphasizing the need for proactive measures in both industrial and domestic settings.
In summary, Salmonella’s survival in harsh conditions hinges on biofilm formation, not spore formation, setting it apart from Bacillus species. This distinction informs effective control strategies, from enhanced cleaning protocols to the use of biofilm-disrupting agents. By targeting biofilms, we can mitigate Salmonella’s persistence and reduce the risk of foodborne outbreaks, safeguarding public health in a world where this pathogen remains a persistent threat.
Mastering Peaceful Spore Strategies: Tips for Dominating Without Conflict
You may want to see also

Heat Resistance: Salmonella is heat-sensitive; spore-formers like Clostridium botulinum are more heat-resistant
Salmonella's vulnerability to heat is a critical factor in food safety, but it’s not the only player in the game. While Salmonella is effectively eliminated at temperatures above 60°C (140°F) for 10–15 minutes, spore-forming bacteria like *Clostridium botulinum* require far more extreme measures. These spores can survive boiling temperatures (100°C or 212°F) for hours, making them a persistent threat in improperly processed foods. This stark contrast in heat resistance highlights why understanding the type of pathogen you’re dealing with is essential for effective food preservation.
For home cooks and food processors, this difference translates into specific practices. To kill Salmonella, thorough cooking or pasteurization is usually sufficient. For instance, heating poultry to an internal temperature of 74°C (165°F) ensures Salmonella is destroyed. However, when dealing with spore-formers like *C. botulinum*, methods such as pressure canning at 121°C (250°F) for 30 minutes are necessary to eliminate spores. This is why low-acid canned goods, which can harbor *C. botulinum*, must be processed under high pressure and temperature, while acidified foods like pickles are less risky.
The heat sensitivity of Salmonella also influences food storage and reheating practices. Reheating leftovers to at least 74°C (165°F) can effectively kill any Salmonella present, but it won’t address spore-forming bacteria if they’ve already germinated. For example, leaving cooked rice at room temperature allows *Bacillus cereus* spores to activate, and reheating won’t destroy the toxins they produce. This underscores the importance of proper cooling and storage to prevent spore germination in the first place.
From a public health perspective, the heat resistance of pathogens dictates regulatory standards. Food safety guidelines often focus on time-temperature combinations that target the most heat-resistant organisms present. For Salmonella, these standards are relatively achievable, but for spore-formers, they require industrial-grade equipment and precision. This is why home canning of low-acid foods is discouraged unless a pressure canner is used—boiling water alone isn’t enough to destroy *C. botulinum* spores.
In summary, while Salmonella’s heat sensitivity makes it manageable with standard cooking practices, spore-formers demand more rigorous methods. Recognizing this difference is key to preventing foodborne illnesses. Whether you’re cooking a meal or preserving food, understanding the heat resistance of the pathogens involved ensures safety and efficacy. Always follow evidence-based guidelines, and when in doubt, opt for methods proven to eliminate the most resilient organisms.
Spore's Effectiveness Against the Wolf of Saturn Six: A Detailed Analysis
You may want to see also

Food Safety Implications: Non-spore forming nature of Salmonella limits its survival in processed foods compared to spore-formers
Salmonella, a notorious foodborne pathogen, lacks the ability to form spores, a trait that significantly influences its survival in processed foods. Unlike spore-forming bacteria such as Clostridium botulinum or Bacillus cereus, which can withstand extreme conditions like high heat and desiccation, Salmonella is more vulnerable to processing methods commonly used in the food industry. This non-spore forming nature means that Salmonella relies on vegetative cells for survival, which are less resilient to adverse environments. As a result, food safety strategies often capitalize on this weakness to minimize Salmonella contamination.
Consider thermal processing, a cornerstone of food preservation. While spore-forming bacteria require extreme temperatures (often exceeding 121°C) and prolonged heating to ensure destruction, Salmonella is effectively eliminated at much lower temperatures and shorter durations. For instance, pasteurization at 63°C for 30 minutes or cooking to an internal temperature of 75°C can significantly reduce Salmonella populations. This makes it easier to control Salmonella in processed foods like poultry, eggs, and dairy products compared to spore-formers, which may survive such treatments and germinate under favorable conditions later.
However, the non-spore forming nature of Salmonella does not render it harmless in all processed foods. Cross-contamination remains a critical risk, especially in ready-to-eat products where recontamination post-processing can occur. For example, Salmonella introduced during slicing or packaging of deli meats can survive without further heat treatment, posing a direct risk to consumers. Here, stringent hygiene practices and hazard analysis critical control points (HACCP) systems are essential to prevent reintroduction of the pathogen.
Another implication is the differential survival of Salmonella in low-moisture foods. While spore-forming bacteria can persist in dry environments for years, Salmonella’s survival is limited in such conditions. However, it can still survive for weeks or months in low-moisture foods like spices, nuts, and cereals, particularly if stored improperly. Proper storage conditions, such as maintaining low humidity and temperature, are crucial to further reduce its viability. For instance, storing spices at temperatures below 15°C can inhibit Salmonella growth, whereas spore-formers may remain dormant and unaffected.
In summary, the non-spore forming nature of Salmonella offers a strategic advantage in food safety, as it is more susceptible to common processing methods compared to spore-formers. However, this does not eliminate the need for rigorous control measures, particularly to prevent cross-contamination and ensure proper storage. By understanding these limitations, food manufacturers and consumers can implement targeted strategies to mitigate Salmonella risks effectively, leveraging its vulnerabilities to enhance food safety.
Toxic Mold Spores: Can They Stick to Clothing and Skin?
You may want to see also
Frequently asked questions
No, Salmonella is not a spore-forming bacteria. It is a non-spore-forming, Gram-negative bacterium.
Salmonella cannot survive in extreme conditions as effectively as spore-forming bacteria. It relies on favorable environments for survival and growth.
Knowing that Salmonella is not spore-forming is important because it helps in understanding its susceptibility to heat, disinfection, and other control measures, unlike spore-forming bacteria that can withstand harsh conditions.

